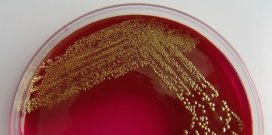

De MRSA-stam die in ziekenhuizen voorkomt heeft zich aangepast aan het ziekenhuis. Deze bacterie is bestand tegen meerdere soorten antibiotica, maar groeit daardoor langzamer.
Dat is een van de conclusies van een Europees onderzoek geleid door het UMC Utrecht.
Antibiotica
De bacterie is bestand tegen meerdere antibiotica, maar groeit daardoor langzamer. Het betekent dat de bacterie moeilijk te bestrijden is in het ziekenhuis, maar dat hij zich daarbuiten nauwelijks verspreidt.
MRSA in ziekenhuizen
‘Het lijkt erop dat we MRSA in Nederlandse ziekenhuizen goed in de hand hebben’, zegt microbioloog Ad Fluit die het onderzoek leidde. ‘Maar de bacterie is genetisch flexibel en kan zich makkelijk aanpassen aan nieuwe omstandigheden.’ MRSA blijft volgens Fluit een risico. ‘Een oplossing bestaat nog niet, maar isolatie van patiënten in ziekenhuizen en terughoudend omgaan met antibiotica is de enige manier om de bacterie binnen de perken te houden.’
Onderzoek
Het UMC Utrecht voerde het onderzoek uit in samenwerking met acht Europese onderzoeksgroepen, onder andere van de Universiteit Utrecht en de Universiteit van Amsterdam. De Europese Unie financierde het CONCORD-project.
Auteur: Redactie TvZ
Bron: UMC Utrecht
Geef je reactie
Om te kunnen reageren moet je inlogd zijn. Inloggen Ik heb nog geen account